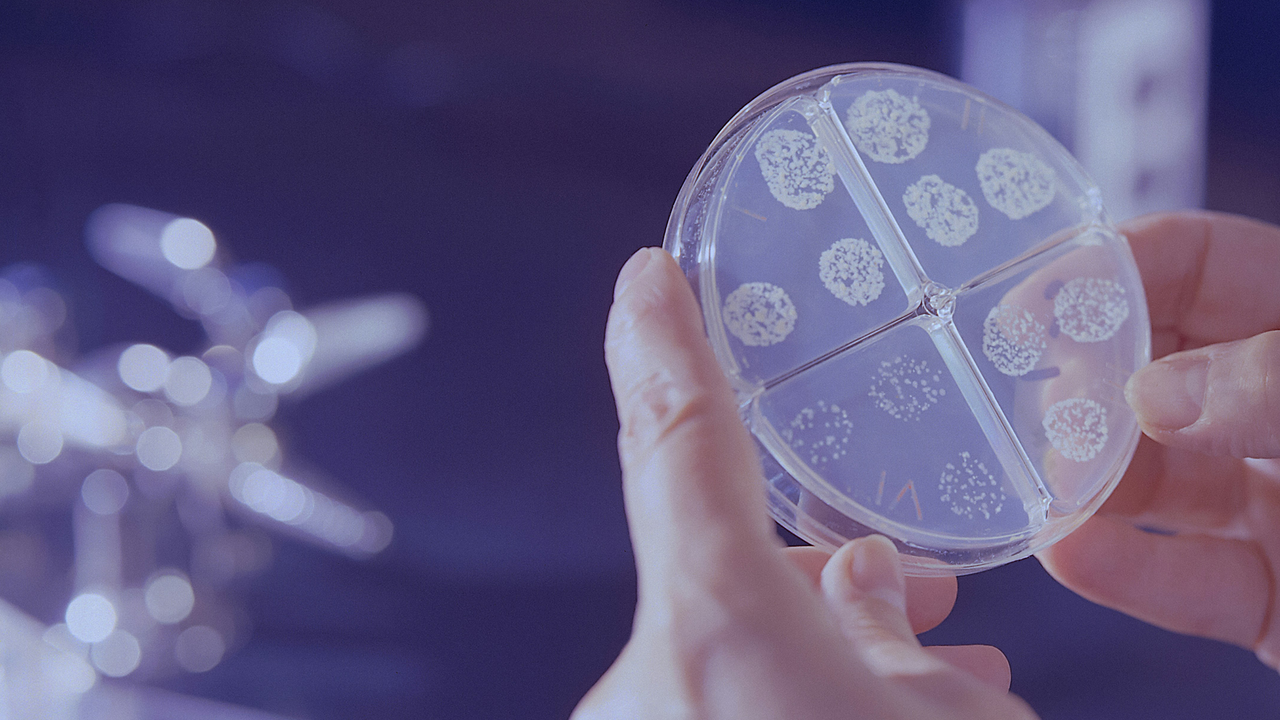

Über 26.000 Stiftungen ergänzen in Deutschland das Handeln des Staates.*
Seit 2019 folgt die Heinz und Heide Dürr Stiftung dem Gründungsmotiv, dass eine Gesellschaft nur dann funktioniert, wenn sich ihre Mitglieder für sie engagieren.
*Quelle: Bundesverband Deutscher Stiftungen, 2025